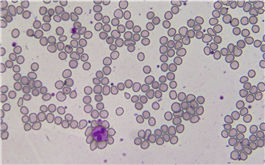

HD Lite (HDMI)


Hot Products

Dhyana 95V2 (BSI )

Dhyana 400BSI V2 (BSI)

FL-20BW (Cooled, Mono)

TrueChrome 4K Pro (HDMI)

TrueChrome AF (HDMI)
Product Categories
sCMOS series
HDMI series
CMOS series
Software Support
Customized Service